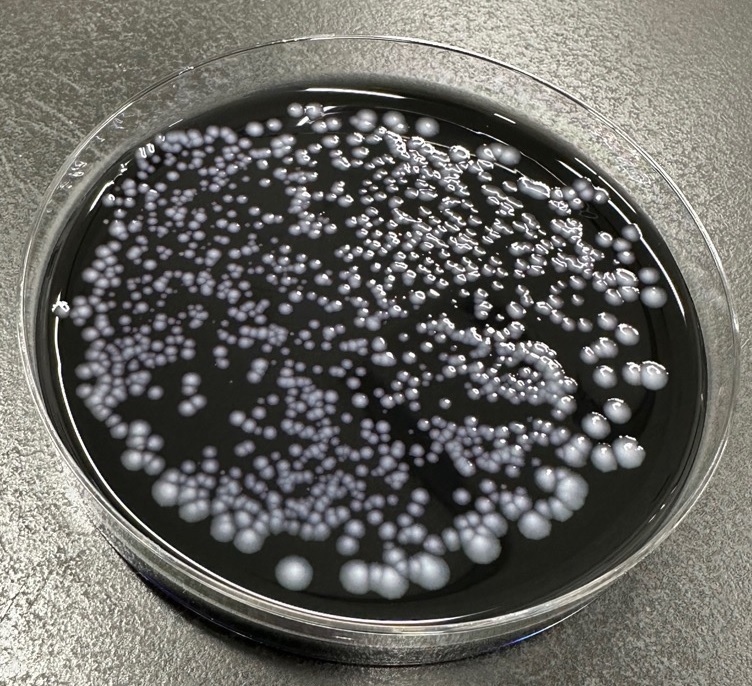

保健所検査課【浴槽水(レジオネラ属菌等)・プール水検査】
登録日:2026年4月6日
ホーム検査受付保菌検査飲用水検査食品検査業務紹介(微生物)業務紹介(理化学)よくある質問
浴槽水(レジオネラ属菌等)・プール水検査について
浴槽水におけるレジオネラ属菌等の検査やプール水の検査を受け付けています。
⒈ 検査項目・検査手数料
| 検査項目 | 検査手数料 | |
|---|---|---|
| 浴槽水 |
浴槽水セット (濁度、有機物、大腸菌、レジオネラ属菌) |
13,850円 |
| レジオネラ属菌 | 7,410円 | |
| 大腸菌 | 3,050円 | |
| プール水 |
pH、濁度、過マンガン酸カリウム消費量、 大腸菌、一般細菌 |
10,700円 |
※検査手数料は、検体をお持ちになった際にお支払いいただきます。
⒉ 検査のご依頼者
- どなた様でもご依頼可能です。
- 入浴施設やデイサービス等の自主検査を希望している方などから依頼いただいております。
⒊ 申し込み方法
- 検査依頼書と採水容器をお渡ししますので、平日の8時30分から17時の間に一度、保健所検査課(4階)までお越し下さい。
※予約の必要はありません。
- 採水後、検査受付日(原則、月~水曜日)の8時30分から15時までの間に、検査依頼書・採水容器・検査手数料を保健所検査課(4階)にお持ち下さい。
※検査受付日は決まっておりますので、次の「浴槽水検査受付日(令和8年度)」または「プール水検査受付日(令和8年度)」をご確認ください。
⒋ 結果の通知
- 通常、レジオネラ属菌が含まれる検査の場合は1週間後、その他の項目のみの場合はご依頼のあった週内に郵送(投かん)となります。
※窓口でのお受け取りをご希望の場合は、検査申込時にお伝えください。
※保健所生活衛生課 環境衛生係に結果を検査課から直接提出することができます。ご希望の方は、受付時にお申し付けください。

⒌ 注意事項
- 採水は検査当日に行ってください。
- 浴槽にお湯をはり、表層部のお湯を採水してください。
- 採水後は、採水容器に直射日光を当てないようにして、直ちに保健所検査課(4階)にお持ちください。
- レジオネラ属菌は、検査に1週間以上要するため、検査成績書の提出期限等がある方は計画的に検査依頼されることをおすすめします。

このページに関するお問い合わせ先
保健福祉部 保健所検査課
電話番号: 0246-27-8598 ファクス: 0246-27-8601
